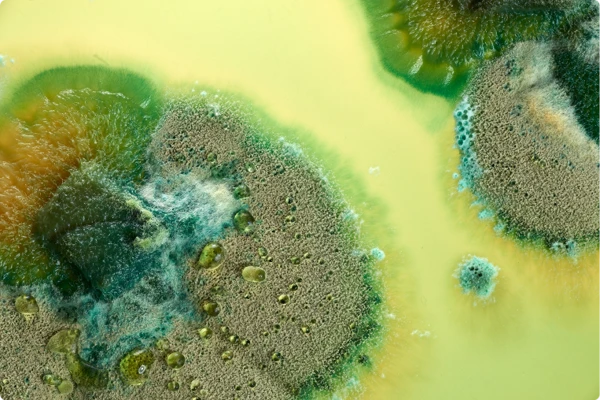
Biology

We conduct water risk assessments annually to identify sites situated in areas with a high – or extremely high – risk of water stress. Our assessments examine water stress–related issues across availability, quality, and accessibility, alongside site-level operational risks to capture local conditions and contexts. We also evaluate physical risks, including droughts and flooding, as well as potential reputational risks. To understand future impacts, we assess both business-as-usual and pessimistic climate scenarios.